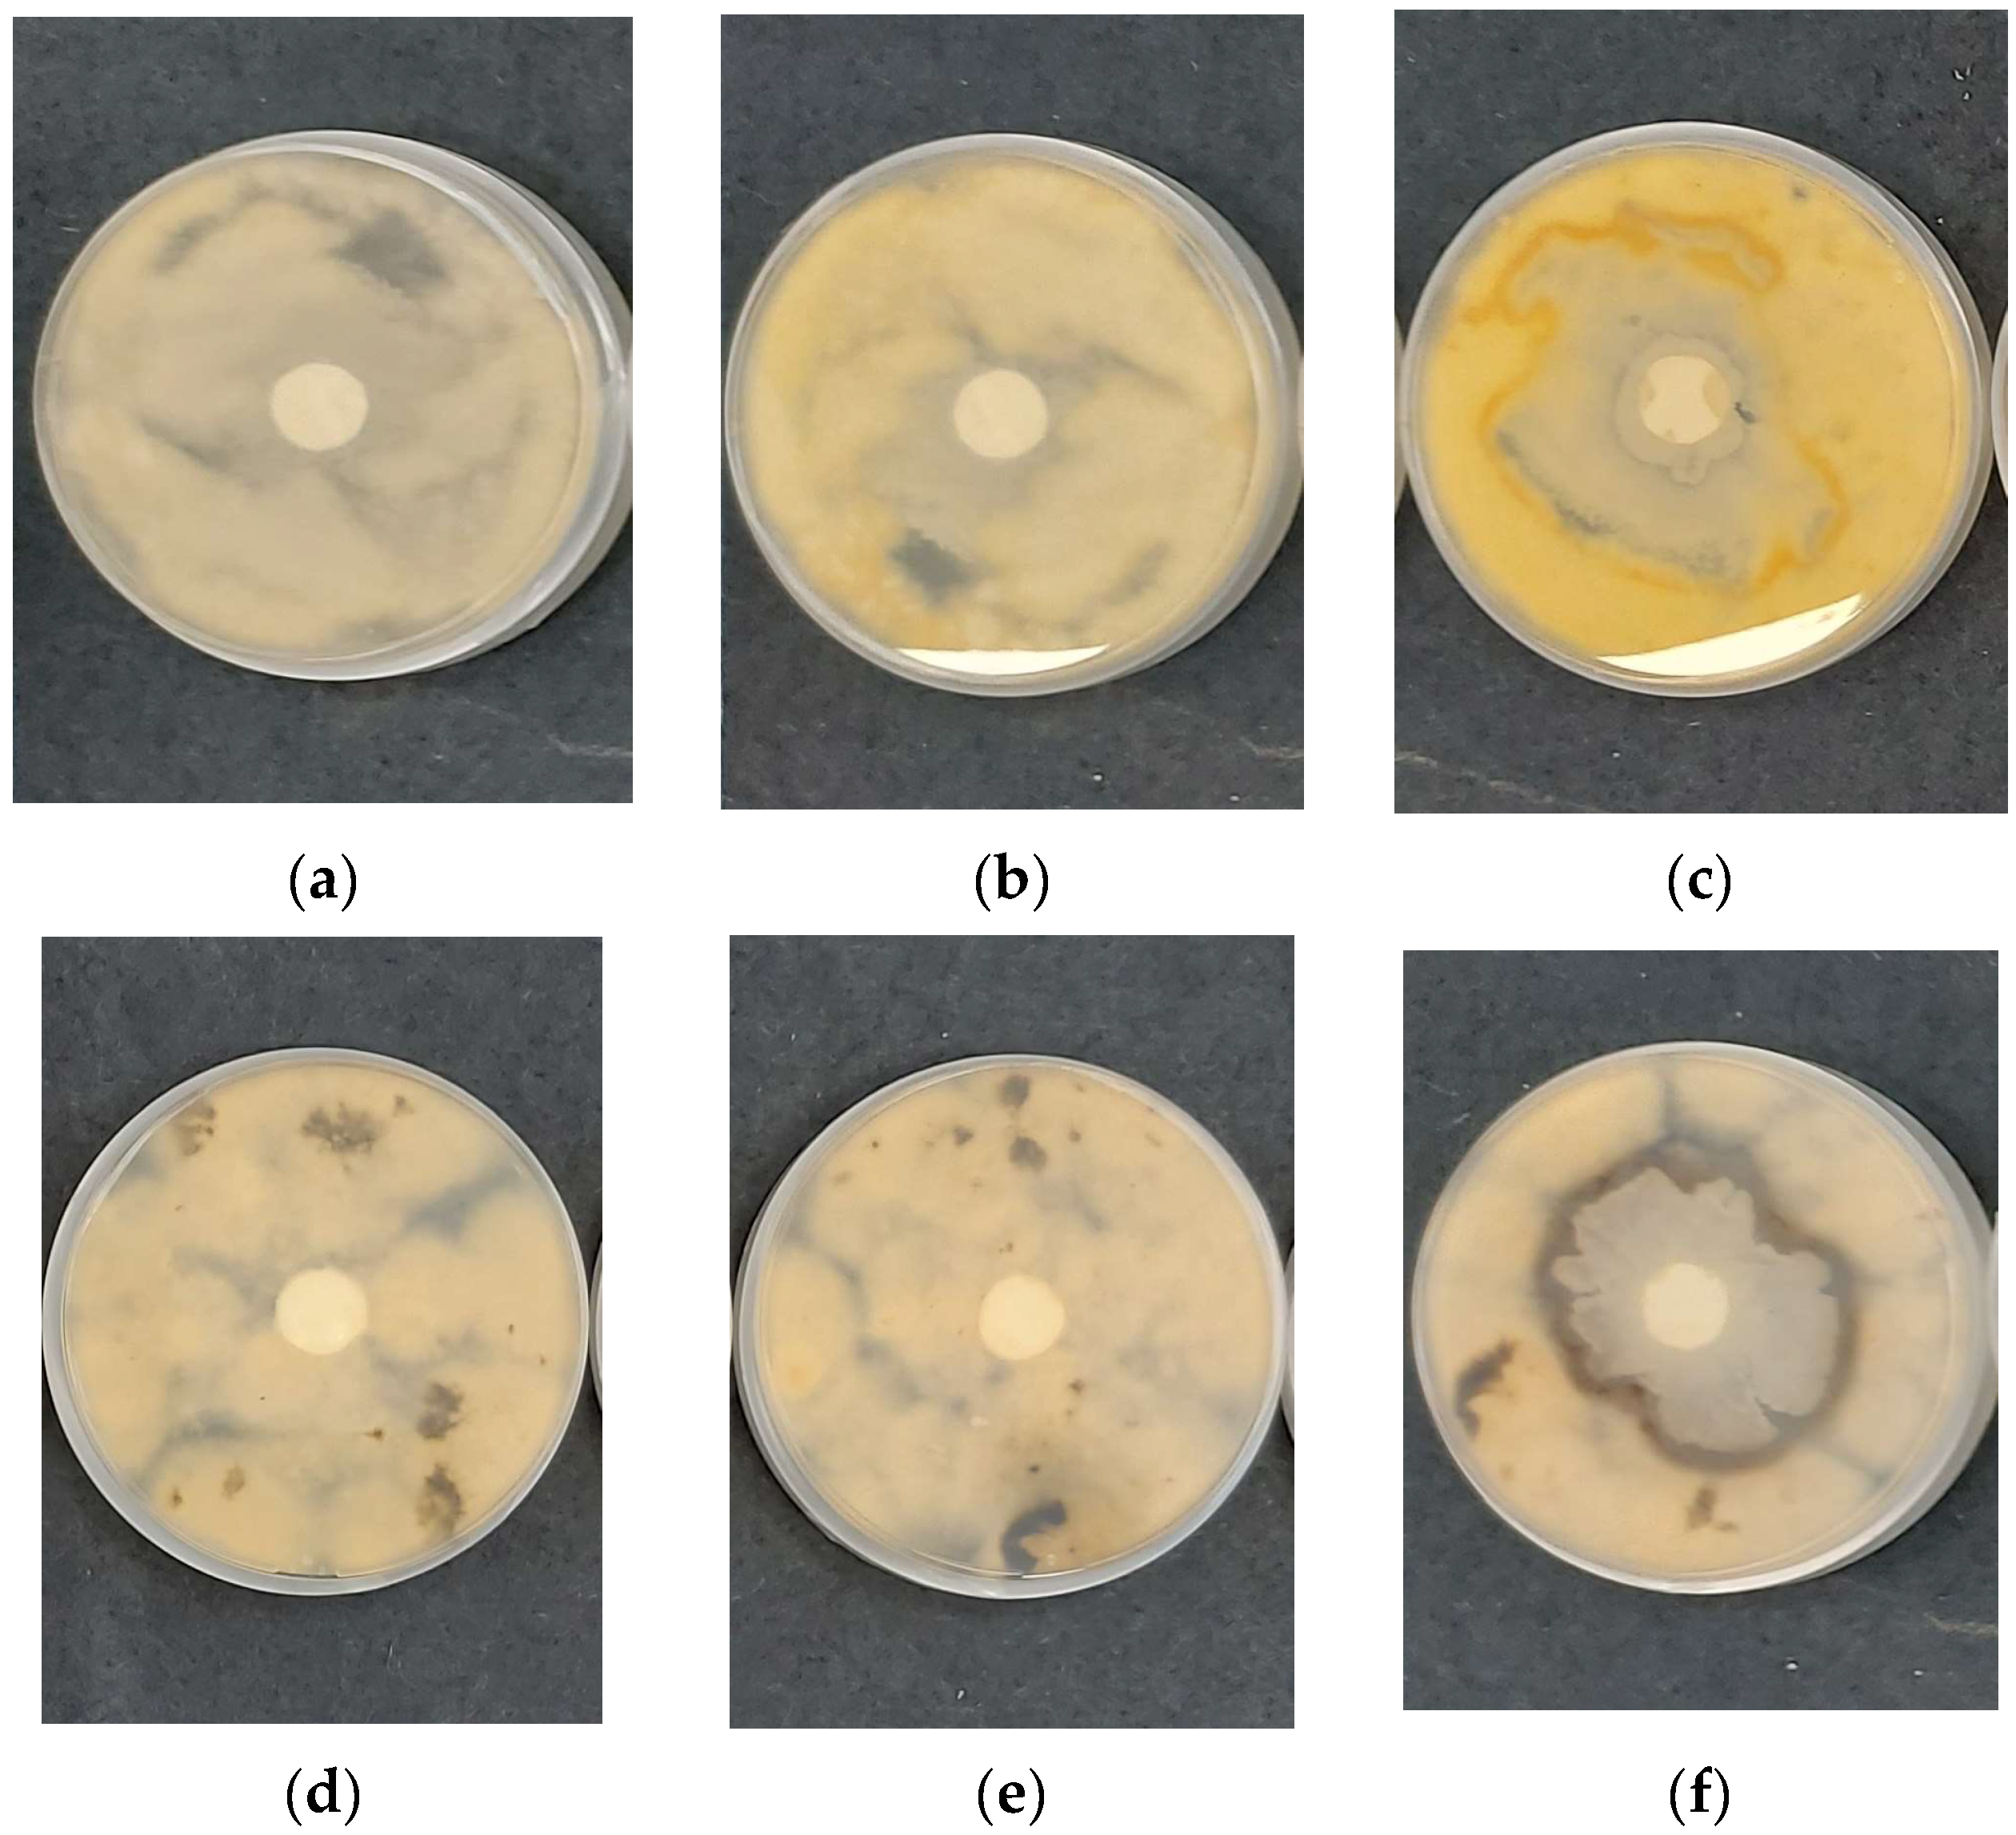
Polymers 17 00692 g009

Biocontrol Potential of Poly(3-hydroxybutyrate) Fibers Functionalized with Chitooligosaccharide/Bacillus subtilis Using Electrospinning and Electrospraying
Abstract
1. Introduction
2. Materials and Methods
2.1. Materials
2.2. Preparation of Electrospun PHB Fibers Coated with Electrosprayed COS and COS/Bacillus subtilis
2.3. Detailed Characterization
2.4. Microbiological Studies
2.5. Analysis of Statistical Data
3. Results and Discussion
3.1. Morphology, Chemical Composition, and Wettability
3.2. Tensile Properties
3.3. Morphology of the Prepared PHB Coated with Electrosprayed COS/B. subtilis Mats
3.4. Evaluation of Viability of Embedded Spores in Fibrous Biohybrids
3.5. Two-Strain Culture Analysis
4. Conclusions
Author Contributions
Funding
Institutional Review Board Statement
Data Availability Statement
Acknowledgments
Conflicts of Interest
References
- Gai, Y.; Wang, H. Plant Disease: A Growing Threat to Global Food Security. Agronomy 2024, 14, 1615. [Google Scholar] [CrossRef]
- Summuna, B.; Gupta, S.; Gupta, M. Plant Diseases: A Potential Threat to Global Food Security. Asia-Pac. J. Food Saf. Secur. 2015, 1, 15–24. Available online: https://www.researchgate.net/publication/325896796 (accessed on 22 September 2015).
- Srisakrapikoop, U.; Pirie, T.J.; Fellowes, M.D.E. Meta-Analysis Suggests Differing Indirect Effects of Viral, Bacterial, and Fungal Plant Pathogens on the Natural Enemies of Insect Herbivores. Insects 2020, 11, 765. [Google Scholar] [CrossRef] [PubMed]
- Zhang, B.; Lv, F.; Yang, J. Pesticides Toxicity, Removal and Detoxification in Plants: A Review. Agronomy 2024, 14, 1260. [Google Scholar] [CrossRef]
- Tudi, M.; Li, H.; Li, H.; Wang, L.; Lyu, J.; Yang, L.; Tong, S.; Yu, Q.J.; Ruan, H.D.; Atabila, A.; et al. Exposure Routes and Health Risks Associated with Pesticide Application. Toxics 2022, 10, 335. [Google Scholar] [CrossRef]
- Góngora, C.E.; Silva, M.d.C. Sustainable Strategies for the Control of Crop Diseases and Pests to Reduce Pesticides. Agronomy 2024, 14, 2158. [Google Scholar] [CrossRef]
- Nchu, F. Sustainable Biological Control of Pests: The Way Forward. Appl. Sci. 2024, 14, 2669. [Google Scholar] [CrossRef]
- Tyagi, A.; Lama Tamang, T.; Kashtoh, H.; Mir, R.A.; Mir, Z.A.; Manzoor, S.; Manzar, N.; Gani, G.; Vishwakarma, S.K.; Almalki, M.A.; et al. A Review on Biocontrol Agents as Sustainable Approach for Crop Disease Management: Applications, Production, and Future Perspectives. Horticulturae 2024, 10, 805. [Google Scholar] [CrossRef]
- Lahlali, R.; Ezrari, S.; Radouane, N.; Kenfaoui, J.; Esmaeel, Q.; El Hamss, H.; Belabess, Z.; Barka, E.A. Biological Control of Plant Pathogens: A Global Perspective. Microorganisms 2022, 10, 596. [Google Scholar] [CrossRef]
- Lee, J.; Kim, S.; Jung, H.; Koo, B.; Han, J.; Lee, H. Exploiting Bacterial Genera as Biocontrol Agents: Mechanisms, Interactions and Applications in Sustainable Agriculture. J. Plant Biol. 2003, 66, 485–498. [Google Scholar] [CrossRef]
- Karačić, V.; Miljaković, D.; Marinković, J.; Ignjatov, M.; Milošević, D.; Tamindžić, G.; Ivanović, M. Bacillus Species: Excellent Biocontrol Agents against Tomato Diseases. Microorganisms 2024, 12, 457. [Google Scholar] [CrossRef]
- Riseh, R.S.; Hassanisaadi, M.; Vatankhah, M.; Soroush, F.; Varma, R.S. Nano/microencapsulation of Plant Biocontrol Agents by Chitosan, Alginate, and Other Important Biopolymers as a Novel Strategy for Alleviating Plant Biotic Stresses. Int. J. Biol. Macromol. Part A 2022, 222, 1589–1604. [Google Scholar] [CrossRef] [PubMed]
- Riseh, R.S.; Tamanadar, E.; Hajabdollahi, N.; Vatankhah, M.; Thakur, V.K.; Skorik, Y.A. Chitosan Microencapsulation of Rhizobacteria for Biological Control of Plant Pests and Diseases: Recent Advances and Applications. Rhizosphere 2022, 23, 100565. [Google Scholar] [CrossRef]
- Stoilova, O.; Koseva, N.; Petrova, T.; Manolova, N.; Rashkov, I.; Naydenov, M. Hydrolysis of Chitosan, Chitosan-Polyoxyethylene and Chitosan-poly (2-acryloylamido-2-methylpropanesulfonic acid) by a Crude Enzyme Complex from Trichoderma viride. J. Bioact. Compat. 2001, 16, 379–392. [Google Scholar] [CrossRef]
- Patel, A.K.; Michaud, P.; de Baynast, H.; Grédiac, M.; Mathias, J.D. Preparation of Chitosan-based Adhesives and Assessment of Their Mechanical Properties. J. Appl. Polym. Sci. 2013, 127, 3869–3876. [Google Scholar] [CrossRef]
- Liang, S.; Sun, Y.; Dai, X. A review of the Preparation, Analysis and Biological Functions of Chitooligosaccharide. Int. J. Mol. Sci. 2018, 19, 2197. [Google Scholar] [CrossRef]
- Spasova, M.; Manolova, N.; Rashkov, I.; Naydenov, M. Eco-Friendly Hybrid PLLA/Chitosan/Trichoderma asperellum Nanomaterials as Biocontrol Dressings against Esca Disease in Grapevines. Polymers 2022, 14, 2356. [Google Scholar] [CrossRef]
- Tsekova, P.; Nachev, N.; Valcheva, I.; Draganova, D.; Naydenov, M.; Spasova, M.; Stoilova, O. Encapsulation of Bacillus subtilis in Electrospun Poly(3-hydroxybutyrate) Fibers Coated with Cellulose Derivatives for Sustainable Agricultural Applications. Polymers 2024, 16, 2749. [Google Scholar] [CrossRef]
- Krastev, V.; Stoyanova, N.; Valcheva, I.; Draganova, D.; Naydenov, M.; Spasova, M.; Stoilova, O. Development of Chitosan-Coated Electrospun Poly(3-hydroxybutyrate) Biohybrid Materials for Growth and Long-Term Storage of Bacillus subtilis. Polysaccharides 2024, 5, 698–714. [Google Scholar] [CrossRef]
- Korina, E.; Stoilova, O.; Manolova, N.; Rashkov, I. Multifunctional Hybrid Materials from Poly(3-hydroxybutyrate), TiO2 Nanoparticles, and Chitosan Oligomers by Combining Electrospinning/Electrospraying and Impregnation. Macromol Biosci. 2013, 13, 707–716. [Google Scholar] [CrossRef]
- Spasova, M.; Stoilova, O.; Manolova, N.; Rashkov, I.; Naydenov, M. Eco-friendly PHB/TiO2 Fibrous Materials with Antifungal Activity Prepared by Electrospinning/Electrospraying Techniques. Polymers 2020, 12, 1384. [Google Scholar] [CrossRef]
- Jaworek, A. Electrospray Droplet Sources for Thin Film Deposition. J. Mater. Sci. 2007, 42, 266–297. [Google Scholar] [CrossRef]
- Korina, E.; Stoilova, O.; Manolova, N.; Rashkov, I. Poly(3-hydroxybutyrate)-based Hybrid Materials with Photocatalytic and Magnetic Properties prepared by Electrospinning and Electrospraying. J. Mater. Sci. 2014, 49, 2144–2153. [Google Scholar] [CrossRef]
- Korina, E.; Stoilova, O.; Manolova, N.; Rashkov, I. Polymer Fibers with Magnetic Core Decorated with Titanium Dioxide Prospective for Photocatalytic Water Treatment. J. Environ. Chem. Eng. 2018, 6, 2075–2084. [Google Scholar] [CrossRef]
- Gali, K.; Soundararajan, N.; Katiyar, V.; Sivaprakasam, S. Electrospun Chitosan Coated Polylactic Acid Nanofiber: A Novel Immobilization Matrix for a—Amylase and its Application in Hydrolysis of Cassava Fibrous Waste. J. Mater. Res. Technol. 2021, 13, 686–699. [Google Scholar] [CrossRef]
- Akinsemolu, A.A.; Onyeaka, H.; Odion, S. Exploring Bacillus subtilis: Ecology, Biotechnological Applications, and Future Prospects. J. Basic Microbiol. 2024, 64, 2300614. [Google Scholar] [CrossRef]
- Blanco Crivelli, X.; Cundon, C.; Bonino, M.P.; Sanin, M.S.; Bentancor, A. The Complex and Changing Genus Bacillus: A Diverse Bacterial Powerhouse for Many Applications. Bacteria 2024, 3, 256–270. [Google Scholar] [CrossRef]
- Khan, A.R.; Mustafa, A.; Hyder, S.; Valipour, M.; Rizvi, Z.F.; Gondal, A.S.; Yousuf, Z.; Iqbal, R.; Daraz, U. Bacillus spp. as Bioagents: Uses and Application for Sustainable Agriculture. Biology 2022, 11, 1763. [Google Scholar] [CrossRef]
- Kim, S.-H.; Yehuala, G.A.; Bang, W.Y.; Yang, J.; Jung, Y.H.; Park, M.-K. Safety Evaluation of Bacillus subtilis IDCC1101, Newly Isolated from Cheonggukjang, for Industrial Applications. Microorganisms 2022, 10, 2494. [Google Scholar] [CrossRef]
- Ashwini, N.; Srividya, S. Potentiality of Bacillus subtilis as Biocontrol Agent for Management of Anthracnose Disease of Chilli Caused by Colletotrichum gloeosporioides OGC1. 3 Biotech 2014, 4, 127–136. [Google Scholar] [CrossRef]
- Schiro, G.; Verch, G.; Grimm, V.; Müller, M.E.H. Alternaria and Fusarium Fungi: Differences in Distribution and Spore Deposition in a Topographically Heterogeneous Wheat Field. J. Fungi 2018, 4, 63. [Google Scholar] [CrossRef] [PubMed]
- Schiro, G.; Müller, T.; Verch, G.; Sommerfeld, T.; Mauch, T.; Koch, M.; Grimm, V.; Müller, M.E.H. The Distribution of Mycotoxins in a Heterogeneous Wheat Field in Relation to Microclimate, Fungal and Bacterial Abundance. Appl. Microbiol. 2019, 126, 177–190. [Google Scholar] [CrossRef] [PubMed]
- Fraeyman, S.; Croubels, S.; Devreese, M.; Antonissen, G. Emerging Fusarium and Alternaria Mycotoxins: Occurrence, Toxicity and Toxicokinetics. Toxins 2017, 9, 228. [Google Scholar] [CrossRef] [PubMed]

Disclaimer/Publisher’s Note: The statements, opinions and data contained in all publications are solely those of the individual author(s) and contributor(s) and not of MDPI and/or the editor(s). MDPI and/or the editor(s) disclaim responsibility for any injury to people or property resulting from any ideas, methods, instructions or products referred to in the content. |
© 2025 by the authors. Licensee MDPI, Basel, Switzerland. This article is an open access article distributed under the terms and conditions of the Creative Commons Attribution (CC BY) license (https://creativecommons.org/licenses/by/4.0/).
Share and Cite
Stoyanova, N.; Nachev, N.; Naydenov, M.; Valcheva, I.; Spasova, M.; Stoilova, O. Biocontrol Potential of Poly(3-hydroxybutyrate) Fibers Functionalized with Chitooligosaccharide/Bacillus subtilis Using Electrospinning and Electrospraying. Polymers 2025, 17, 692. https://doi.org/10.3390/polym17050692
Stoyanova N, Nachev N, Naydenov M, Valcheva I, Spasova M, Stoilova O. Biocontrol Potential of Poly(3-hydroxybutyrate) Fibers Functionalized with Chitooligosaccharide/Bacillus subtilis Using Electrospinning and Electrospraying. Polymers. 2025; 17(5):692. https://doi.org/10.3390/polym17050692
Chicago/Turabian StyleStoyanova, Nikoleta, Nasko Nachev, Mladen Naydenov, Iliyana Valcheva, Mariya Spasova, and Olya Stoilova. 2025. "Biocontrol Potential of Poly(3-hydroxybutyrate) Fibers Functionalized with Chitooligosaccharide/Bacillus subtilis Using Electrospinning and Electrospraying" Polymers 17, no. 5: 692. https://doi.org/10.3390/polym17050692
APA StyleStoyanova, N., Nachev, N., Naydenov, M., Valcheva, I., Spasova, M., & Stoilova, O. (2025). Biocontrol Potential of Poly(3-hydroxybutyrate) Fibers Functionalized with Chitooligosaccharide/Bacillus subtilis Using Electrospinning and Electrospraying. Polymers, 17(5), 692. https://doi.org/10.3390/polym17050692







